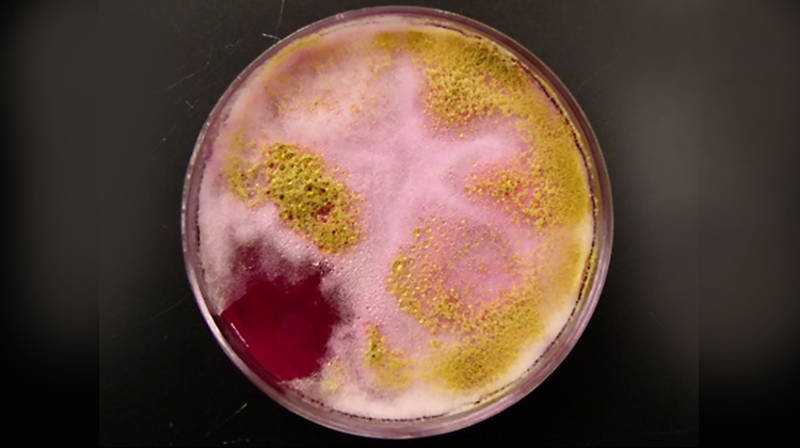
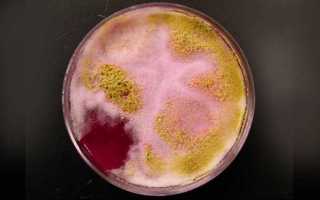

Бак. посев мочи на чувствительность к антибиотикам
Для определения оптимального способа терапии можно использовать анализ культуры на его чувствительность к различным антибиотикам. Его результат называется также антибиотикограммой.
В чём заключается суть данного исследования? Нужно разделить на части чашку Петри и поместить в каждую полоску или кружок, пропитанные антибиотиком. Маркировка их осуществляется либо с внешней стороны чашки, либо по цвету.
Чистую культуру засевают в сектора. Затем чашку ставят в термостат, имеющий температуру тела человека, и ежедневно контролируют. Если антибиотик идеальный, то он убьёт бактерии, и в секторе не будет роста. В случае же устойчивости возбудителя будет отмечен рост колонии.
Чтобы получить результат, нужно подождать от четырёх до пяти дней. Благодаря новым методам можно выполнить исследование за два дня, при этом будет определена не только чувствительность препаратов, но и их лечебная доза.
Мы выяснили, что показывает анализ мочи на посев.
Врачи подчеркивают важность правильной подготовки к бактериологическому посеву мочи для получения точных результатов. Перед сдачей анализа рекомендуется провести гигиеническую обработку половых органов, чтобы избежать загрязнения образца. Пациентам советуют использовать стерильные контейнеры и собирать среднюю порцию мочи, что позволяет минимизировать риск попадания бактерий из уретры.
Расшифровка результатов анализа может варьироваться в зависимости от выявленных микроорганизмов и их количества. Нормой считается отсутствие патогенных бактерий, однако, если они обнаружены, врач анализирует их вид и чувствительность к антибиотикам. Это позволяет назначить адекватное лечение. Важно помнить, что интерпретация результатов должна проводиться квалифицированным специалистом, который учтет клиническую картину и сопутствующие симптомы пациента.
Бак посев мочи — это важный анализ, который помогает выявить инфекции мочевыводящих путей. Люди часто отмечают, что правильная подготовка к сдаче анализа играет ключевую роль в получении достоверных результатов. Рекомендуется собирать утреннюю порцию мочи в стерильный контейнер, избегая предварительных гигиенических процедур, которые могут исказить данные.
После сдачи анализа результаты обычно готовы через несколько дней. Пациенты часто интересуются, что означают полученные значения. Например, наличие бактерий указывает на инфекцию, а их количество помогает определить степень тяжести. Важно помнить, что интерпретацию результатов должен проводить врач, который учтет клиническую картину и симптомы. Правильное понимание анализа позволяет своевременно начать лечение и избежать осложнений.

Где сдать и цена анализа?
- районная поликлиника;
- городская больница;
- специализированные лаборатории;
- медицинские научные центры.
Сдать мочу на анализ можно как в частной лаборатории, так и в государственной больнице
В государственной больнице процедура осуществляется бесплатно, в частных лабораториях анализ платный. Исходя из категории медицинского учреждения и уровня профессионализма персонала, средняя цена бакпосева с антибиотикограммой составляет 670 р. В платных диагностических центрах можно сделать срочный анализ. Стоимость экспресс-посева мочи будет выше – от 800 р.
Исследование мочи на стерильность и бактерии с высокой точностью выявляет возбудителя воспалительного процесса в мочевыделительной системе, его вид и чувствительность к антибактериальным препаратам. На результаты анализа влияют подготовка и сбор материала, при заборе урины важно соблюдать рекомендации врача.
Сдать анализ реально как в обычной больнице, так и в частной лаборатории. Получить на руки результаты можно через 5–7 рабочих дней.
Заболевания
Вопрос-ответ

Как расшифровать результат анализа на посев мочи?
Расшифровка анализа Норма: «негативный результат» — рост бактерий не наблюдается или определяется его низкая концентрация. Количественное содержание микроорганизмов <, 103 КОЕ/мл свидетельствует о загрязнении исследуемого образца и считается сомнительным результатом.
Как прочитать бак посев мочи?
Если рост микроорганизмов отсутствует, то результат отрицателен. Если рост бактерий или, например, грибков все же выявлен в такой концентрации, при которой возможно развитие инфекции, то результат бакпосева мочи считается положительным.

Как расшифровывается бак посев?
Микробиологический анализ (бакпосев) кала Микробиологический анализ (бакпосев) – это лабораторное исследование биологических жидкостей на наличие в образцах бактерий, вирусов, грибков и паразитов.
Какой показатель в моче говорит о воспалении?
Присутствие лейкоцитов в количестве более пяти клеток в поле зрения отмечают в следующих случаях: Воспалительные заболевания почек и мочевыводящих путей инфекционной и неинфекционной природы (гломерулонефрит, пиелонефрит, тубулоинтерстициальный нефрит, цистит, уретрит, туберкулез).
Советы
СОВЕТ №1
Перед сдачей анализа убедитесь, что вы правильно подготовились: избегайте употребления антибиотиков и других лекарств за несколько дней до теста, если это не противоречит рекомендациям вашего врача. Также старайтесь не употреблять алкоголь и острые продукты, так как они могут повлиять на результаты.
СОВЕТ №2
Для получения точных результатов важно правильно собрать мочу. Используйте стерильный контейнер, который можно приобрести в аптеке. Перед сбором мочи тщательно вымойте половые органы, чтобы избежать загрязнения образца.
СОВЕТ №3
Собирайте среднюю порцию мочи: начните мочиться в унитаз, затем подставьте контейнер и соберите около 50-100 мл, после чего завершите мочеиспускание в унитаз. Это поможет избежать попадания в образец клеток и бактерий, находящихся на поверхности уретры.
СОВЕТ №4
После сбора мочи постарайтесь как можно быстрее доставить образец в лабораторию, желательно в течение 1-2 часов. Если это невозможно, храните контейнер в холодильнике, но не дольше 24 часов, чтобы минимизировать изменения в составе мочи.